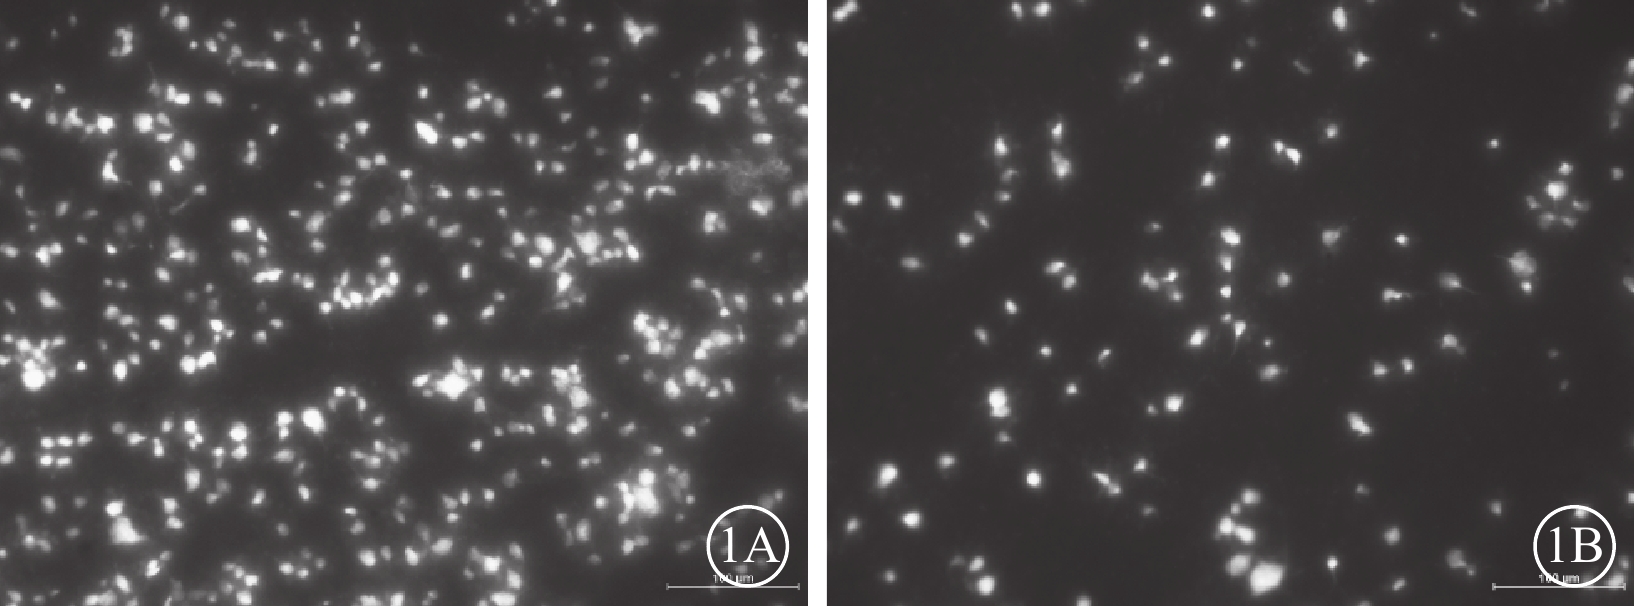

引用本文: 干霖洋, 崔建濤, 丑玉宇, 汪宇涵, 杜虹, 李東輝, 戴威, 張宏, 張棟, 馬瑾, 鐘勇. 苯扎托品對大鼠非動脈炎性前部缺血性視神經病變模型神經保護作用初探. 中華眼底病雜志, 2019, 35(3): 259-262. doi: 10.3760/cma.j.issn.1005-1015.2019.03.010 復制
非動脈炎性前部缺血性視神經病變(NAION)是由于篩板前視神經急性缺血而導致的視神經疾病,主要表現為急性無痛性視力下降、特征性視野缺損以及視盤水腫等,目前尚無有效治療方法。研究表明,RGC凋亡、軸突損傷是導致NAION患者視功能損傷的直接原因,而視神經軸突周圍髓鞘的損傷是引起RGC凋亡的原因之一[1]。因此,抑制髓鞘細胞的凋亡、促進其再生可能是治療NAION的潛在方法。由于難以獲得NAION患者的臨床病理標本,NAION動物模型(rNAION)為探討NAION病理機制及探索治療策略即具有重要意義[2-3]。既往研究已證實,rNAION眼底視盤改變、FFA、OCT和電生理特點均與NAION患者的臨床特征基本一致[4-7]。苯扎托品(Benztropine)為一種抗膽堿藥物,通過抑制M受體,可以誘導少突膠質細胞的分化,促進髓鞘再生[8]。為此,本研究借鑒光動力方法制備rNAION模型,初步探索苯扎托品對rNAION模型視神經保護的潛在作用。現將結果報道如下。
1 材料和方法
健康雄性Spargue-Dawley大鼠25只,鼠齡8周,體重180~200 g,無特定病原體級;由中國醫學科學院北京協和醫院實驗動物中心飼養于標準(12 h光/暗循環)清潔級環境中。飼養環境及實驗操作均符合國家科學技術委員會《實驗動物管理條例》的規定,并獲得北京協和醫院動物倫理委員會許可(倫理編號:XHDW-2017-004)。實驗前常規飼養4 d,并經散瞳檢查排除眼部疾病。
采用光動力方法建立rNAION模型,以右眼為實驗眼。按體重0.4 ml/100 g的劑量腹腔注射10%水合氯醛麻醉大鼠,復方托吡卡胺滴眼液充分散瞳,鹽酸奧布卡因點眼。將大鼠置于VISULAS眼底激光機(德國蔡司公司)前,激光參數:波長532 nm,能量50 mW,光斑直徑500 μm。按體重1 ml/kg的劑量經股靜脈注入2.5 mmol/L光敏劑孟加拉玫瑰紅(RB,美國Sigma公司),并對準視盤照射12 s[9]。建模后直接檢眼鏡觀察眼底,排除眼底出血或視網膜大血管阻塞。
建模后當天,采用隨機數字表法將大鼠分為苯扎托品干預組、PBS對照組,分別為13、12只大鼠;左眼為正常對照組。苯扎托品干預組大鼠按體重10 mg/kg的劑量腹腔注射10 mg/ml的苯扎托品溶液0.2 ml[8],PBS對照組大鼠腹腔注射等體積PBS;1次/d,連續21 d。建模后1、3、7 d直接檢眼鏡檢查觀察大鼠視盤情況。
建模后21 d,隨機選取苯扎托品干預組、PBS對照組9、8只大鼠,麻醉后將其頭部固定于腦立體定位儀上,沿正中線切開顱頂皮膚,確定Bregma點[10],其后移5.9、6.4 mm,旁開1.4 mm分別定位雙側上丘。微型顱鉆在相應定位點鉆開顱骨。微量注射器將3%熒光金(美國Biotium公司)緩慢注入各孔。熒光金標記后7 d(建模后28 d),麻醉大鼠摘取眼球置于4%多聚甲醛中固定2 h,分離視網膜并鋪片,分別于鼻上、顳上、鼻下、顳下方向剪開形成4個象限。熒光顯微鏡觀察,分別在4個象限以距視盤2 mm處為中心采集圖像,每張圖像實際面積為0.3 mm2。2名研究者分別采用ImageJ軟件盲法人工計數RGC。并換算成RGC密度(RGC計數除以圖像面積)。將右眼與左眼RGC密度的比值定義為RGC存活率[6]。
同時隨機選取苯扎托品干預組、PBS對照組各4只大鼠。將其麻醉后,心臟灌注,4%多聚甲醛固定液、2%戊二醛固定。摘取還有視神經的眼球標本,置入2.5%戊二醛溶液后固定過夜。顯微鏡下去除眼前節,留取視神經及環視盤周圍全層眼球壁,PBS沖洗,1%鋨酸固定,梯度酒精脫水,環氧樹脂包埋、半薄切片行光鏡定位,制作50 nm超薄切片,醋酸雙氧鈾和枸櫞酸鉛染色。透射電子顯微鏡觀察并照相記錄。
采用SPSS 18.0軟件進行統計學分析。定量資料以均數±標準差( ±s)表示。兩組大鼠RGC密度及存活率比較采用單因素方差分析。P<0.05為差異有統計學意義。
±s)表示。兩組大鼠RGC密度及存活率比較采用單因素方差分析。P<0.05為差異有統計學意義。
2 結果
建模后1、3 d,rNAION模型組大鼠視盤水腫,邊界欠清晰;建模后7 d,視盤水腫較建模后3 d時減退,邊界模糊。正常對照組大鼠視盤無水腫、隆起。
建模后28 d,熒光顯微鏡觀察發現,苯扎托品組干預組、PBS對照組大鼠左眼RGC密度分別為(2325±348)、(2205±397)個/mm2;兩組間差異無統計學意義(F=0.440,P=0.517)。苯扎托品干預組大鼠右眼熒光點分布有所減少,但仍較密集(圖1A),RGC密度為(1173±868)個/mm2,RGC存活率為47.6%。PBS組大鼠右眼熒光點分布稀疏(圖1B),RGC密度分別為(308±194)個/mm2,RGC存活率為13.7%;兩組大鼠右眼RGC存活率比較,差異有統計學意義(F=8.184,P=0.012)。
 圖1
兩組大鼠RGC熒光顯微鏡像。1A、2B分別示苯扎托品干預組、PBS對照組。苯扎托品干預組大鼠右眼熒光點分布有所減少,但仍較密集。PBS對照組大鼠右眼熒光點分布稀疏 標尺:100 μm
圖1
兩組大鼠RGC熒光顯微鏡像。1A、2B分別示苯扎托品干預組、PBS對照組。苯扎托品干預組大鼠右眼熒光點分布有所減少,但仍較密集。PBS對照組大鼠右眼熒光點分布稀疏 標尺:100 μm
透射電子顯微鏡觀察發現,正常對照組大鼠視神經纖維束結構完整,可見大小不等的軸突規則排列,髓鞘明顯。建模后28 d,PBS對照組大鼠視神經髓鞘解體,軸突消失,可見“洋蔥樣”小體、膠質增生(圖2A,2B);苯扎托品干預組大鼠多數軸突和髓鞘結構基本完整(圖2C,2D),破壞程度較PBS組明顯減輕。
 圖2
大鼠視神經超微結構透射電子顯微鏡像。2A、2B分別示PBS對照組。2A示視神經大量髓鞘解體,軸突潰變,膠質瘢痕形成 標尺:1.0 μm;2B示洋蔥樣小體形成 標尺:0.5 μm。2C、2D分別示苯扎托品干預組。2C示視神經僅見少量髓鞘及軸鎖破壞 標尺:1 μm;2D示髓鞘及軸突結構基本完整 標尺:0.5 μm 醋酸雙氧鈾和枸櫞酸鉛
圖2
大鼠視神經超微結構透射電子顯微鏡像。2A、2B分別示PBS對照組。2A示視神經大量髓鞘解體,軸突潰變,膠質瘢痕形成 標尺:1.0 μm;2B示洋蔥樣小體形成 標尺:0.5 μm。2C、2D分別示苯扎托品干預組。2C示視神經僅見少量髓鞘及軸鎖破壞 標尺:1 μm;2D示髓鞘及軸突結構基本完整 標尺:0.5 μm 醋酸雙氧鈾和枸櫞酸鉛
3 討論
rNAION模型的建立為探討NAION病理機制及神經保護創造了條件。本研究所采用的建模方法與臨床上光動力療法的原理相近,近年來已被用于NAION等疾病的研究[5]。以靜脈注射RB作為光敏劑,配合波長532 nm的Fd-YAG激光照射建模應用最為普遍[5]。由于RB血液濃度下降較快,注射后須在1 min內完成激光照射。本實驗為在前期實驗基礎[6, 10-11]上的后續研究,模型制作人員固定,RB注射后1 min內順利完成激光照射,有助于提高rNAION模型損傷程度的穩定性。既往研究發現,大鼠建模后初期出現視神經組織水腫及炎癥反應,之后出現RGC及其軸突的丟失,與臨床患者的表現類似[4-5]。建模后眼底檢查結果以及FFA、OCT、視覺電生理及組織病理學上的改變與臨床患者類似[3-7]。
本研究分析了RGC的存活率和視神經超顯微結構的改變,初步驗證了苯扎托品對NAION大鼠的視神經保護作用。苯扎托品干預組大鼠腹腔連續注射苯扎托品21 d,28 d時右眼RGC密度為(1173±868)個/mm2,存活率為47.6%。而PBS對照組大鼠右眼RGC密度僅為(308±194)個/mm2,存活率為13.7%,明顯低于苯扎托品干預組。
視神經由RGC的軸突匯集組成,軟腦膜緊貼在視神經周圍,并伸出結締組織小梁與神經膠質構成間隔,將視神經分為許多神經纖維束。本研究透射電子顯微鏡觀察發現,大鼠正常視神經纖維束結構完整,可見大小不等的軸突,髓鞘明顯。PBS對照組大鼠視神經髓鞘解體、軸突變性,正常組織由膠質增生取代;苯扎托品干預組大鼠視神經髓鞘崩解和軸突變性程度明顯輕于PBS對照組。
既往相關文獻報道,誘導早期首先表現為少突膠質細胞功能障礙,2~3 d后可出現少突膠質細胞凋亡及脫髓鞘改變[1];而RGC的凋亡和軸突崩解則出現在缺血后1周左右, 2~3周達高峰[1, 12]。少突膠質細胞對神經元胞體及軸突的存活、髓鞘化十分重要,其功能障礙可能帶來多米諾骨諾效應,引起視神經的進行性軸突損害。越來越多地證據表明NAION的脫髓鞘改變并不能完全用軸突丟失后的繼發性反應進行解釋,很有可能是軸突和RGC減少的原因之一。
既往研究發現神經系統出現脫髓鞘改變后,裸露的軸膜上表達更多的N-型電壓門控鈣通道,過量鈣離子內流導致軸突損傷[13]。此外, 脫髓鞘還可導致神經絲蛋白磷酸化水平降低, 軸突內蛋白骨架穩定性下降, 脫髓鞘部位軸突斷裂崩解, 出現沃勒變性[14]。除缺血性改變外,單純地沃勒變性也會誘導氧化應激[15],導致線粒體功能受損,并啟動線粒體凋亡信號通路,造成神經細胞的丟失[16]。
Deshmukh等[8]研究發現,苯扎托品在多發性硬化模型中具有神經保護作用,能夠誘導少突膠質細胞的分化,促進髓鞘再生。少突膠質細胞參與形成中樞神經系統軸突的髓鞘,雖然確切作用機制尚不完全明確,但有研究顯示其可以分泌神經營養因子,在維持神經元及軸突的存活中具有重要作用[17-18]。NAION病理過程中,RGC的脫髓鞘與其軸突的凋亡有一定的關系,我們推測苯扎托品正是通過誘導少突膠質細胞的分化,維持視神經髓鞘的完整性并促進其再生,從而減少RGC軸突的凋亡,對rNAION起到保護作用。
本研究初步探索了苯扎托品對rNAION模型大鼠的視神經保護保護作用。結果表明苯扎托品治療組RGC存活率和視神經軸突、髓鞘破壞較對照組明顯改善。但本研究存在以下不足:觀察指標和時間點較單一;未進行視功能的評估;視神經結構改變無法定量。后續研究中將完善RGC及少突膠質細胞凋亡檢測,并將從分子生物學水平觀察苯扎托品對少突膠質細胞功能的影響。
非動脈炎性前部缺血性視神經病變(NAION)是由于篩板前視神經急性缺血而導致的視神經疾病,主要表現為急性無痛性視力下降、特征性視野缺損以及視盤水腫等,目前尚無有效治療方法。研究表明,RGC凋亡、軸突損傷是導致NAION患者視功能損傷的直接原因,而視神經軸突周圍髓鞘的損傷是引起RGC凋亡的原因之一[1]。因此,抑制髓鞘細胞的凋亡、促進其再生可能是治療NAION的潛在方法。由于難以獲得NAION患者的臨床病理標本,NAION動物模型(rNAION)為探討NAION病理機制及探索治療策略即具有重要意義[2-3]。既往研究已證實,rNAION眼底視盤改變、FFA、OCT和電生理特點均與NAION患者的臨床特征基本一致[4-7]。苯扎托品(Benztropine)為一種抗膽堿藥物,通過抑制M受體,可以誘導少突膠質細胞的分化,促進髓鞘再生[8]。為此,本研究借鑒光動力方法制備rNAION模型,初步探索苯扎托品對rNAION模型視神經保護的潛在作用。現將結果報道如下。
1 材料和方法
健康雄性Spargue-Dawley大鼠25只,鼠齡8周,體重180~200 g,無特定病原體級;由中國醫學科學院北京協和醫院實驗動物中心飼養于標準(12 h光/暗循環)清潔級環境中。飼養環境及實驗操作均符合國家科學技術委員會《實驗動物管理條例》的規定,并獲得北京協和醫院動物倫理委員會許可(倫理編號:XHDW-2017-004)。實驗前常規飼養4 d,并經散瞳檢查排除眼部疾病。
采用光動力方法建立rNAION模型,以右眼為實驗眼。按體重0.4 ml/100 g的劑量腹腔注射10%水合氯醛麻醉大鼠,復方托吡卡胺滴眼液充分散瞳,鹽酸奧布卡因點眼。將大鼠置于VISULAS眼底激光機(德國蔡司公司)前,激光參數:波長532 nm,能量50 mW,光斑直徑500 μm。按體重1 ml/kg的劑量經股靜脈注入2.5 mmol/L光敏劑孟加拉玫瑰紅(RB,美國Sigma公司),并對準視盤照射12 s[9]。建模后直接檢眼鏡觀察眼底,排除眼底出血或視網膜大血管阻塞。
建模后當天,采用隨機數字表法將大鼠分為苯扎托品干預組、PBS對照組,分別為13、12只大鼠;左眼為正常對照組。苯扎托品干預組大鼠按體重10 mg/kg的劑量腹腔注射10 mg/ml的苯扎托品溶液0.2 ml[8],PBS對照組大鼠腹腔注射等體積PBS;1次/d,連續21 d。建模后1、3、7 d直接檢眼鏡檢查觀察大鼠視盤情況。
建模后21 d,隨機選取苯扎托品干預組、PBS對照組9、8只大鼠,麻醉后將其頭部固定于腦立體定位儀上,沿正中線切開顱頂皮膚,確定Bregma點[10],其后移5.9、6.4 mm,旁開1.4 mm分別定位雙側上丘。微型顱鉆在相應定位點鉆開顱骨。微量注射器將3%熒光金(美國Biotium公司)緩慢注入各孔。熒光金標記后7 d(建模后28 d),麻醉大鼠摘取眼球置于4%多聚甲醛中固定2 h,分離視網膜并鋪片,分別于鼻上、顳上、鼻下、顳下方向剪開形成4個象限。熒光顯微鏡觀察,分別在4個象限以距視盤2 mm處為中心采集圖像,每張圖像實際面積為0.3 mm2。2名研究者分別采用ImageJ軟件盲法人工計數RGC。并換算成RGC密度(RGC計數除以圖像面積)。將右眼與左眼RGC密度的比值定義為RGC存活率[6]。
同時隨機選取苯扎托品干預組、PBS對照組各4只大鼠。將其麻醉后,心臟灌注,4%多聚甲醛固定液、2%戊二醛固定。摘取還有視神經的眼球標本,置入2.5%戊二醛溶液后固定過夜。顯微鏡下去除眼前節,留取視神經及環視盤周圍全層眼球壁,PBS沖洗,1%鋨酸固定,梯度酒精脫水,環氧樹脂包埋、半薄切片行光鏡定位,制作50 nm超薄切片,醋酸雙氧鈾和枸櫞酸鉛染色。透射電子顯微鏡觀察并照相記錄。
采用SPSS 18.0軟件進行統計學分析。定量資料以均數±標準差( ±s)表示。兩組大鼠RGC密度及存活率比較采用單因素方差分析。P<0.05為差異有統計學意義。
±s)表示。兩組大鼠RGC密度及存活率比較采用單因素方差分析。P<0.05為差異有統計學意義。
2 結果
建模后1、3 d,rNAION模型組大鼠視盤水腫,邊界欠清晰;建模后7 d,視盤水腫較建模后3 d時減退,邊界模糊。正常對照組大鼠視盤無水腫、隆起。
建模后28 d,熒光顯微鏡觀察發現,苯扎托品組干預組、PBS對照組大鼠左眼RGC密度分別為(2325±348)、(2205±397)個/mm2;兩組間差異無統計學意義(F=0.440,P=0.517)。苯扎托品干預組大鼠右眼熒光點分布有所減少,但仍較密集(圖1A),RGC密度為(1173±868)個/mm2,RGC存活率為47.6%。PBS組大鼠右眼熒光點分布稀疏(圖1B),RGC密度分別為(308±194)個/mm2,RGC存活率為13.7%;兩組大鼠右眼RGC存活率比較,差異有統計學意義(F=8.184,P=0.012)。
圖1
兩組大鼠RGC熒光顯微鏡像。1A、2B分別示苯扎托品干預組、PBS對照組。苯扎托品干預組大鼠右眼熒光點分布有所減少,但仍較密集。PBS對照組大鼠右眼熒光點分布稀疏 標尺:100 μm
圖1
兩組大鼠RGC熒光顯微鏡像。1A、2B分別示苯扎托品干預組、PBS對照組。苯扎托品干預組大鼠右眼熒光點分布有所減少,但仍較密集。PBS對照組大鼠右眼熒光點分布稀疏 標尺:100 μm
透射電子顯微鏡觀察發現,正常對照組大鼠視神經纖維束結構完整,可見大小不等的軸突規則排列,髓鞘明顯。建模后28 d,PBS對照組大鼠視神經髓鞘解體,軸突消失,可見“洋蔥樣”小體、膠質增生(圖2A,2B);苯扎托品干預組大鼠多數軸突和髓鞘結構基本完整(圖2C,2D),破壞程度較PBS組明顯減輕。
 圖2
大鼠視神經超微結構透射電子顯微鏡像。2A、2B分別示PBS對照組。2A示視神經大量髓鞘解體,軸突潰變,膠質瘢痕形成 標尺:1.0 μm;2B示洋蔥樣小體形成 標尺:0.5 μm。2C、2D分別示苯扎托品干預組。2C示視神經僅見少量髓鞘及軸鎖破壞 標尺:1 μm;2D示髓鞘及軸突結構基本完整 標尺:0.5 μm 醋酸雙氧鈾和枸櫞酸鉛
圖2
大鼠視神經超微結構透射電子顯微鏡像。2A、2B分別示PBS對照組。2A示視神經大量髓鞘解體,軸突潰變,膠質瘢痕形成 標尺:1.0 μm;2B示洋蔥樣小體形成 標尺:0.5 μm。2C、2D分別示苯扎托品干預組。2C示視神經僅見少量髓鞘及軸鎖破壞 標尺:1 μm;2D示髓鞘及軸突結構基本完整 標尺:0.5 μm 醋酸雙氧鈾和枸櫞酸鉛
3 討論
rNAION模型的建立為探討NAION病理機制及神經保護創造了條件。本研究所采用的建模方法與臨床上光動力療法的原理相近,近年來已被用于NAION等疾病的研究[5]。以靜脈注射RB作為光敏劑,配合波長532 nm的Fd-YAG激光照射建模應用最為普遍[5]。由于RB血液濃度下降較快,注射后須在1 min內完成激光照射。本實驗為在前期實驗基礎[6, 10-11]上的后續研究,模型制作人員固定,RB注射后1 min內順利完成激光照射,有助于提高rNAION模型損傷程度的穩定性。既往研究發現,大鼠建模后初期出現視神經組織水腫及炎癥反應,之后出現RGC及其軸突的丟失,與臨床患者的表現類似[4-5]。建模后眼底檢查結果以及FFA、OCT、視覺電生理及組織病理學上的改變與臨床患者類似[3-7]。
本研究分析了RGC的存活率和視神經超顯微結構的改變,初步驗證了苯扎托品對NAION大鼠的視神經保護作用。苯扎托品干預組大鼠腹腔連續注射苯扎托品21 d,28 d時右眼RGC密度為(1173±868)個/mm2,存活率為47.6%。而PBS對照組大鼠右眼RGC密度僅為(308±194)個/mm2,存活率為13.7%,明顯低于苯扎托品干預組。
視神經由RGC的軸突匯集組成,軟腦膜緊貼在視神經周圍,并伸出結締組織小梁與神經膠質構成間隔,將視神經分為許多神經纖維束。本研究透射電子顯微鏡觀察發現,大鼠正常視神經纖維束結構完整,可見大小不等的軸突,髓鞘明顯。PBS對照組大鼠視神經髓鞘解體、軸突變性,正常組織由膠質增生取代;苯扎托品干預組大鼠視神經髓鞘崩解和軸突變性程度明顯輕于PBS對照組。
既往相關文獻報道,誘導早期首先表現為少突膠質細胞功能障礙,2~3 d后可出現少突膠質細胞凋亡及脫髓鞘改變[1];而RGC的凋亡和軸突崩解則出現在缺血后1周左右, 2~3周達高峰[1, 12]。少突膠質細胞對神經元胞體及軸突的存活、髓鞘化十分重要,其功能障礙可能帶來多米諾骨諾效應,引起視神經的進行性軸突損害。越來越多地證據表明NAION的脫髓鞘改變并不能完全用軸突丟失后的繼發性反應進行解釋,很有可能是軸突和RGC減少的原因之一。
既往研究發現神經系統出現脫髓鞘改變后,裸露的軸膜上表達更多的N-型電壓門控鈣通道,過量鈣離子內流導致軸突損傷[13]。此外, 脫髓鞘還可導致神經絲蛋白磷酸化水平降低, 軸突內蛋白骨架穩定性下降, 脫髓鞘部位軸突斷裂崩解, 出現沃勒變性[14]。除缺血性改變外,單純地沃勒變性也會誘導氧化應激[15],導致線粒體功能受損,并啟動線粒體凋亡信號通路,造成神經細胞的丟失[16]。
Deshmukh等[8]研究發現,苯扎托品在多發性硬化模型中具有神經保護作用,能夠誘導少突膠質細胞的分化,促進髓鞘再生。少突膠質細胞參與形成中樞神經系統軸突的髓鞘,雖然確切作用機制尚不完全明確,但有研究顯示其可以分泌神經營養因子,在維持神經元及軸突的存活中具有重要作用[17-18]。NAION病理過程中,RGC的脫髓鞘與其軸突的凋亡有一定的關系,我們推測苯扎托品正是通過誘導少突膠質細胞的分化,維持視神經髓鞘的完整性并促進其再生,從而減少RGC軸突的凋亡,對rNAION起到保護作用。
本研究初步探索了苯扎托品對rNAION模型大鼠的視神經保護保護作用。結果表明苯扎托品治療組RGC存活率和視神經軸突、髓鞘破壞較對照組明顯改善。但本研究存在以下不足:觀察指標和時間點較單一;未進行視功能的評估;視神經結構改變無法定量。后續研究中將完善RGC及少突膠質細胞凋亡檢測,并將從分子生物學水平觀察苯扎托品對少突膠質細胞功能的影響。






